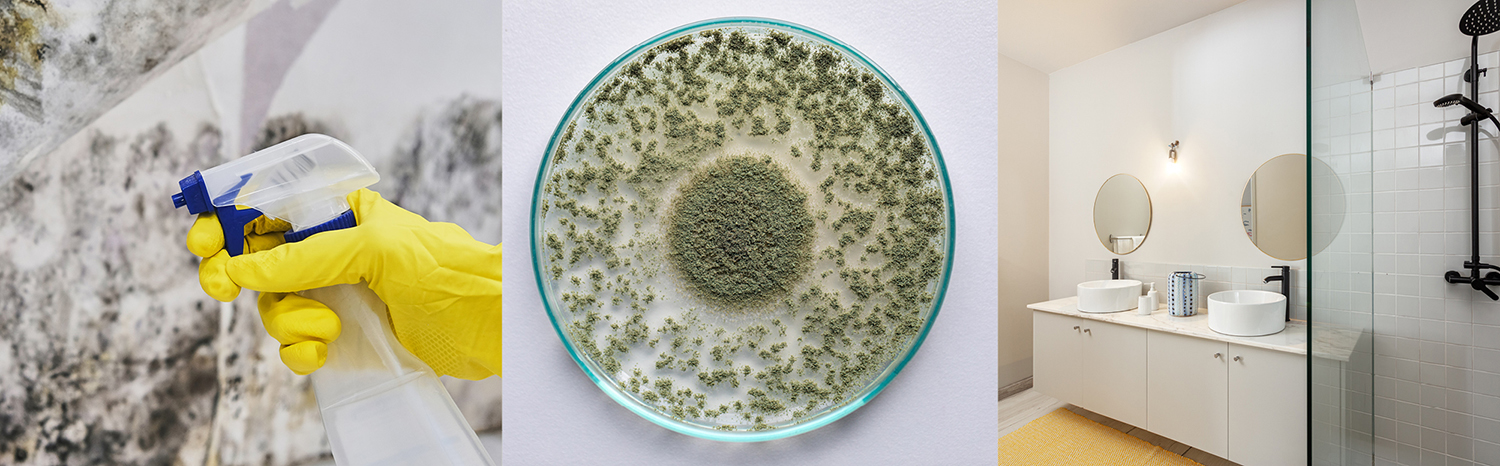

Plijesan i hladni mostovi? Ne čekaj da bude kasno – evo kako ih sanirati i trajno spriječiti
Najčešće se plijesan pojavljuje na mjestima gdje je cirkulacija zraka slaba – u kutovima prostorija, iza ormara i kuhinjskih elemenata, oko prozora ili na vanjskim zidovima. Na tim točkama zrak “stoji”, a zidovi su često hladniji, što stvara savršenu podlogu za razvoj gljivica.
Jedan od glavnih uzroka su hladni mostovi – dijelovi konstrukcije kroz koje toplina brže “bježi” nego kroz ostatak zida. Takvi dijelovi brže se hlade, a kad na njih naiđe topli i vlažni zrak iz prostorije, dolazi do kondenzacije.
Tu dolazimo do drugog problema – visoke vlažnosti i loše ventilacije. Kada u prostoriji vlaga iz kuhanja, tuširanja ili čak disanja nema kamo otići, ona ostaje u zraku. Bez redovite izmjene zraka, ta vlaga se taloži na najhladnijim površinama.
Na kraju, tu je i kondenzacija – prirodan proces koji se događa kada topli, vlažni zrak dotakne hladan zid. Na tim mjestima stvara se tanak sloj vlage, a upravo takvo okruženje idealno je za rast plijesni.
Ukratko, plijesan je rezultat kombinacije građevinskih nedostataka, previše vlage i nedovoljne ventilacije. A iako se ponekad čini kao “samo” vizualni problem, njezina prisutnost može dugoročno utjecati na zdravlje i trajnost vašeg doma.
KORAK 1: Uklonite plijesan i gljivice s površine
Prvi zadatak u borbi protiv plijesni jest uklanjanje onoga što vidite – tamnih mrlja i naslaga na zidovima ili stropovima. No, jednako je važno riješiti se i onoga što ne vidite. Plijesan, naime, proizvodi sitne spore koje se šire zrakom i lako vraćaju problem ako ih ne uništite.
Zato površinu najprije prvo dezinficirajte posebnim pripravcima protiv plijesni ili otopina na bazi alkohola i klora pa potom mehanički očistite – možete koristiti četku, krpu ili spužvu – kako biste uklonili vidljive nakupine. Samo čišćenje bez dezinfekcije znači da će se plijesan vrlo brzo ponovno pojaviti, a sav vaš trud bit će uzaludan.
Predlažemo nekoliko učinkovitih sredstava za borbu protiv plijesni:
PUFAS odstranjivač plijesni s aktivnim klorom – brzo djelujući sprej idealan za kućnu upotrebu koji izbjeljuje površinu. Jednostavno se nanosi i djeluje već nakon nekoliko minuta. Pogodan je za kupaonice, kuhinje i sve prostorije s povremenim problemom vlage.
DRACO CLEAN 600 - sredstvo za čišćenje i odstranjivanje gljivica, plijesni i algi. Ne sadrži klor i kiseline i neizbljeđuje podlogu. Njegova formula prodire duboko u porozne materijale i uklanja i nevidljive slojeve plijesni. Za primjenu na na podnim površinama, pločnicima, fasadama, vrtnom namještaju, zidnim tapetama, žbuci i obojanim površinama.
CAPATOX – Vodena mikrobiocidna otopina za dezinfekciju i bolje čišćenje unutarnjih i vanjskih površina napadnutih algama, mahovinom i plijesni, prije nanošenja premaza koji slijede. Ima dugotrajan učinak i sprječava ponovnu pojavu algi i gljivica.
ALGICID PLUS – dolazi kao gotov sprej ili koncentrat, idealan za manje zahvaćene površine. Brzo uklanja mikroorganizme, a može se koristiti i preventivno.
MAPEI Silancolor Cleaner Plus – za temeljito čišćenje fasada oštećenih gljvicama i plijesni prije bojenja. Posebno se preporučuje za površine koje će kasnije biti prebojene zaštitnim slojem.
Korak 2: Zaštitite zid bojom protiv plijesni
Nakon što ste temeljito očistili i dezinficirali zahvaćene površine, vrijeme je da zidovima pružite dodatni sloj zaštite. Posebne boje protiv plijesni sadrže fungicidna i antibakterijska svojstva koja sprječavaju ponovni razvoj gljivica, čak i u uvjetima veće vlažnosti.
Ovi premazi ne samo da čuvaju estetiku prostora, nego i produžuju vijek trajanja sanacije, jer stvaraju zaštitnu barijeru između zida i vlage. Pravilnim nanošenjem takve boje, na potpuno suhu površinu – značajno smanjujete mogućnost da se plijesan ponovno pojavi na istom mjestu.
Predlažemo nekoliko boja iz našeg asortimana:
JUPOL CITRO – antimikrobna boja s blagim mirisom citrusa. Ugodna je za rad, a pruža dugotrajnu zaštitu od mikroorganizama.
JUPOL AMIKOL – periva lateks boja, izuzetno otporna na vlagu, idealna za kuhinje i kupaonice. Zadržava svjež izgled zidova čak i u zahtjevnim uvjetima.
SCHIMMELX – specijalna bijela boja za dugotrajnu zaštitu protiv vlage i plijesni koja se može tonirati u svijetle tonove.
INDEKO W - unutarnja mat disperzivna boja sa zaštitnim filmom za dugotrajnu zaštitu od plijesni.
FUNGITEX W - specijalna latex boja za premaze s fungicidnim i baktericidnim djelovanjem, a posebno je prikladna za primjenu u vlažnim industrijskim prostorima kao što su pivovare, klaonice, mljekare, bolnice, sanitarni čvorovi kao i stambeni prostori.
ZINSSER PERMA WHITE – akrilna unutarnja boja koja štiti površinu od degradacije gljivicama i plijesni. Posebno razvijena za dugotrajnu otpornost u vlažnim prostorima.
KORAK 3: Spriječite uzrok – izolirajte hladne mostove i smanjite kondenzaciju
Čišćenje i bojanje zidova pomoći će privremeno, ali ako se ne ukloni pravi uzrok, plijesan će se vrlo brzo vratiti. Najčešće se radi o hladnim mostovima – dijelovima konstrukcije kroz koje toplina brže izlazi, a zid postaje hladniji od ostatka prostorije. Upravo tu se vlaga iz zraka najlakše kondenzira i stvara idealne uvjete za rast plijesni.
Rješenje je izolirati kritične dijelove zida, bilo izvana ili iznutra, ovisno o mogućnostima i vrsti objekta. Također, važno je smanjiti razinu vlage u prostoru – redovitim provjetravanjem, korištenjem odvlaživača zraka ili poboljšanjem ventilacije.
Preporučeni proizvodi:
CASAVIVA ANTIKONDENZAT – termo boja koja sprječava kondenzaciju na zidovima. Nanosi se kao završni zidni premaz, koji zidu daje cca. 10 °C veću temperaturu.
JUPOL THERMO – toplinska boja s efektom izolacije, pomaže u smanjenju gubitka topline i stvaranju toplijeg zida.
JUBOLIN THERMO – glet masa s termo svojstvima koja kombinira izravnavanje zidova i izolaciju u jednom koraku.
DRACO SHIELD 600 – termo premaz protiv plijesni i gubitka topline, dodatno poboljšava energetsku učinkovitost prostora, održava površinu toplijom te eliminira hladne mostove.
ECOTHERM premaz – proizvod najsuvremenije nano-tehnologije s izuzetnim termoizolacijskim i reflektirajućim svojstvima daje odlične rezultate pri malim debljinama nanosa i omogućuje da se temperatura ravnomjerno rasporedi i ostane u prostoriji.
PUFATHERM sustav izolacijskih ploča – lagane ploče koje se jednostavno lijepe na zid i stvaraju toplinsku barijeru protiv hladnih mostova.
Ignoriranje prvih znakova vlage ili crnih mrlja na zidu može dovesti do većih i skupljih radova u budućnosti.
Uz pravilan pristup i odgovarajuće proizvode možete:
• Uništiti plijesan i njezine spore, čime sprječavate širenje po cijelom prostoru.
• Zaštititi zidove trajnim premazima i bojama koje odbijaju vlagu i gljivice.
• Spriječiti povratak vlage izolacijom hladnih mostova i kontrolom kondenzacije.
• Povećati energetsku učinkovitost prostora smanjenjem toplinskih gubitaka.
Sanacija plijesni nije kompliciran posao ako se radi planski – prvo uklonite uzrok, zatim očistite i dezinficirajte površinu, a na kraju je zaštitite i ojačajte. Svaki hobi majstor, uz prave informacije i materijale, može izvesti kvalitetnu i dugotrajnu sanaciju.
Ako trebate pomoć naš tim stručnjaka pomoći će vam odabrati pravu kombinaciju proizvoda za vašu situaciju.
Pogledajte cijeli asortiman u našem webshopu ili posjetite poslovnicu i kontaktirajte nas za savjet: info@bacelic.hr